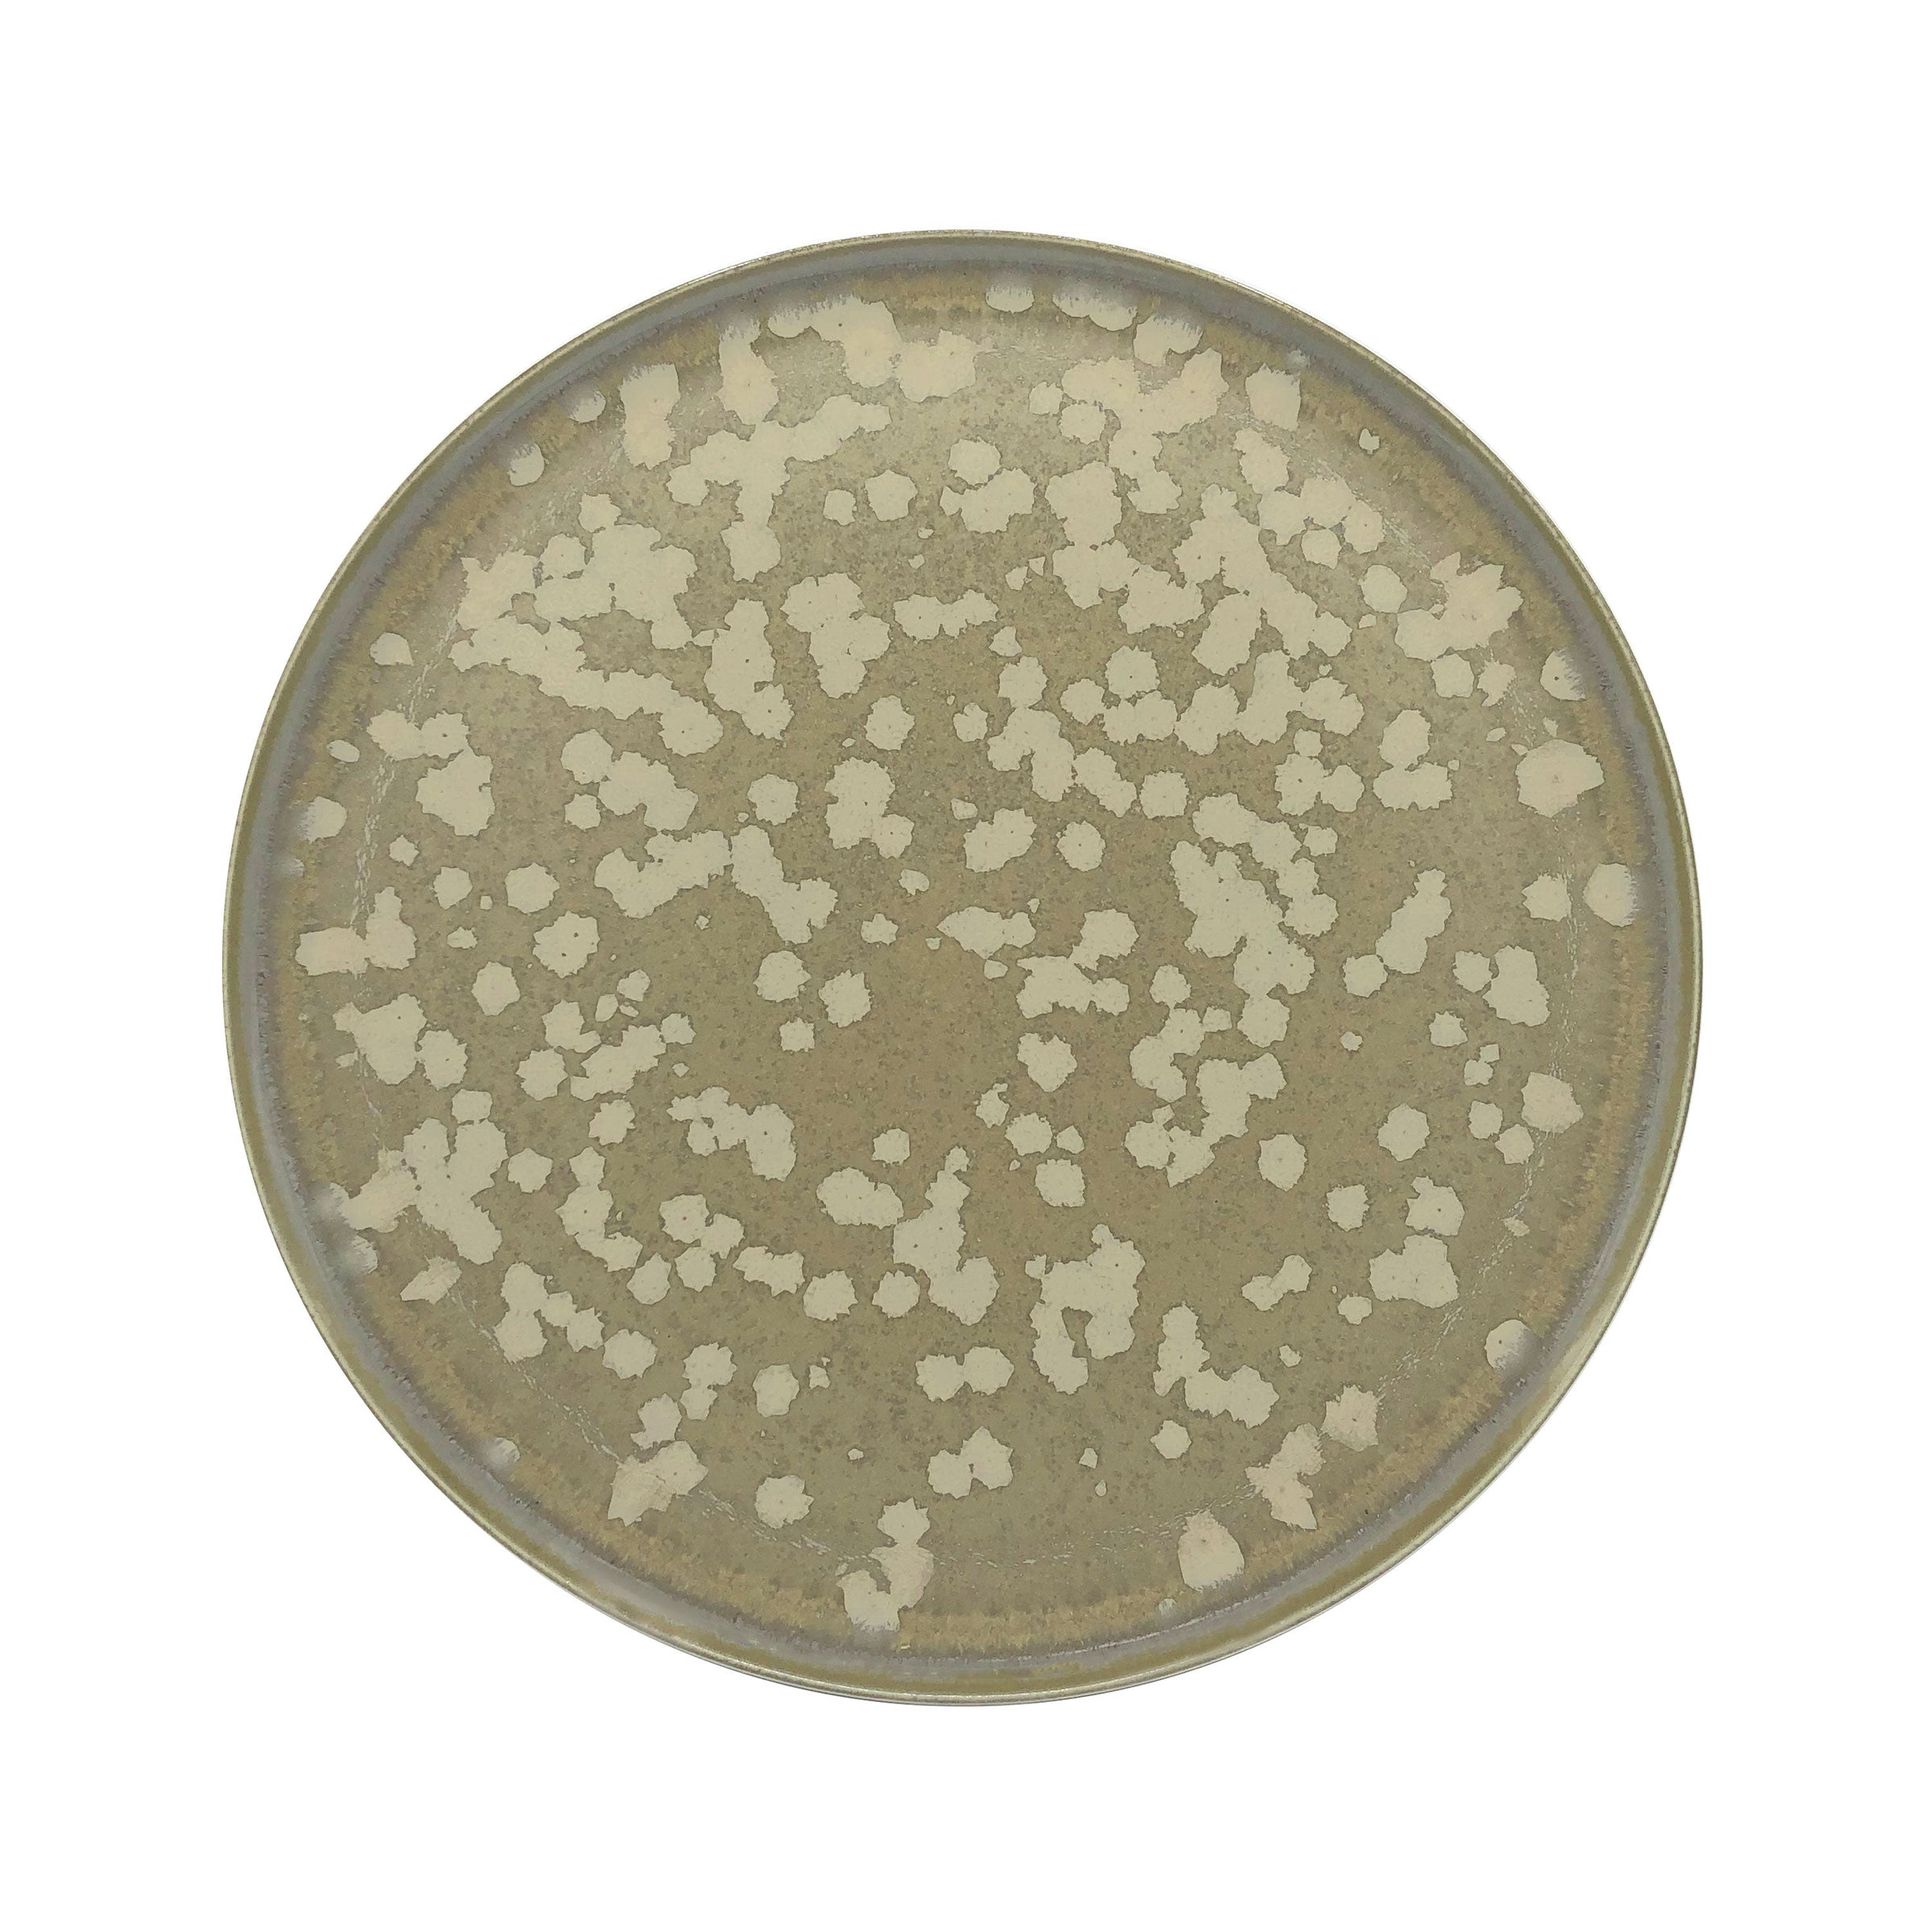
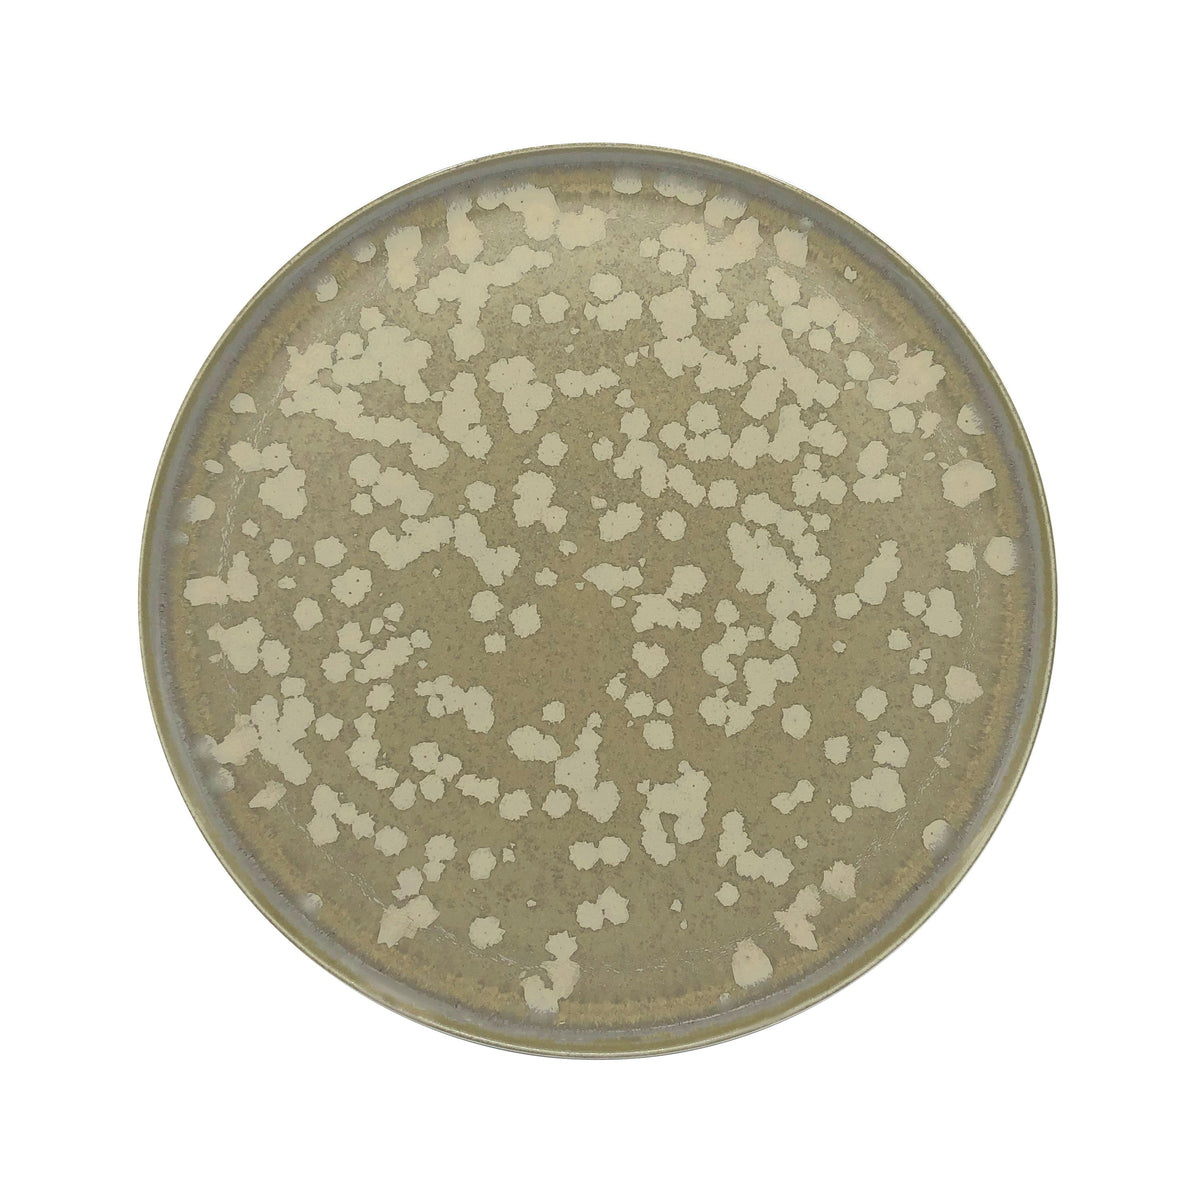
JL Coquet  BASMATI - Assiette plate, Slim 11.42 Inch SKU: SLI1034BASMBLNC000

JL Coquet
JL Coquet BASMATI - Dinner plate, Slim 11.42 Inch SKU: SLI1034BASMBLNC000
- Regular Price
- Sale Price
- Regular Price
- Unit Price
- per
The quintessence of simplicity, purity of form devoid of any artifice, the SLIM plate is ultra-flat, without wings and without basin. With a remarkable aesthetic, the practical side has not been forgotten: the SLIM is distinguished by a very small footprint, for optimized storage for all kitchen sizes. Its slight rim will allow an easy grip, to ensure optimal service in the dining room or at home.